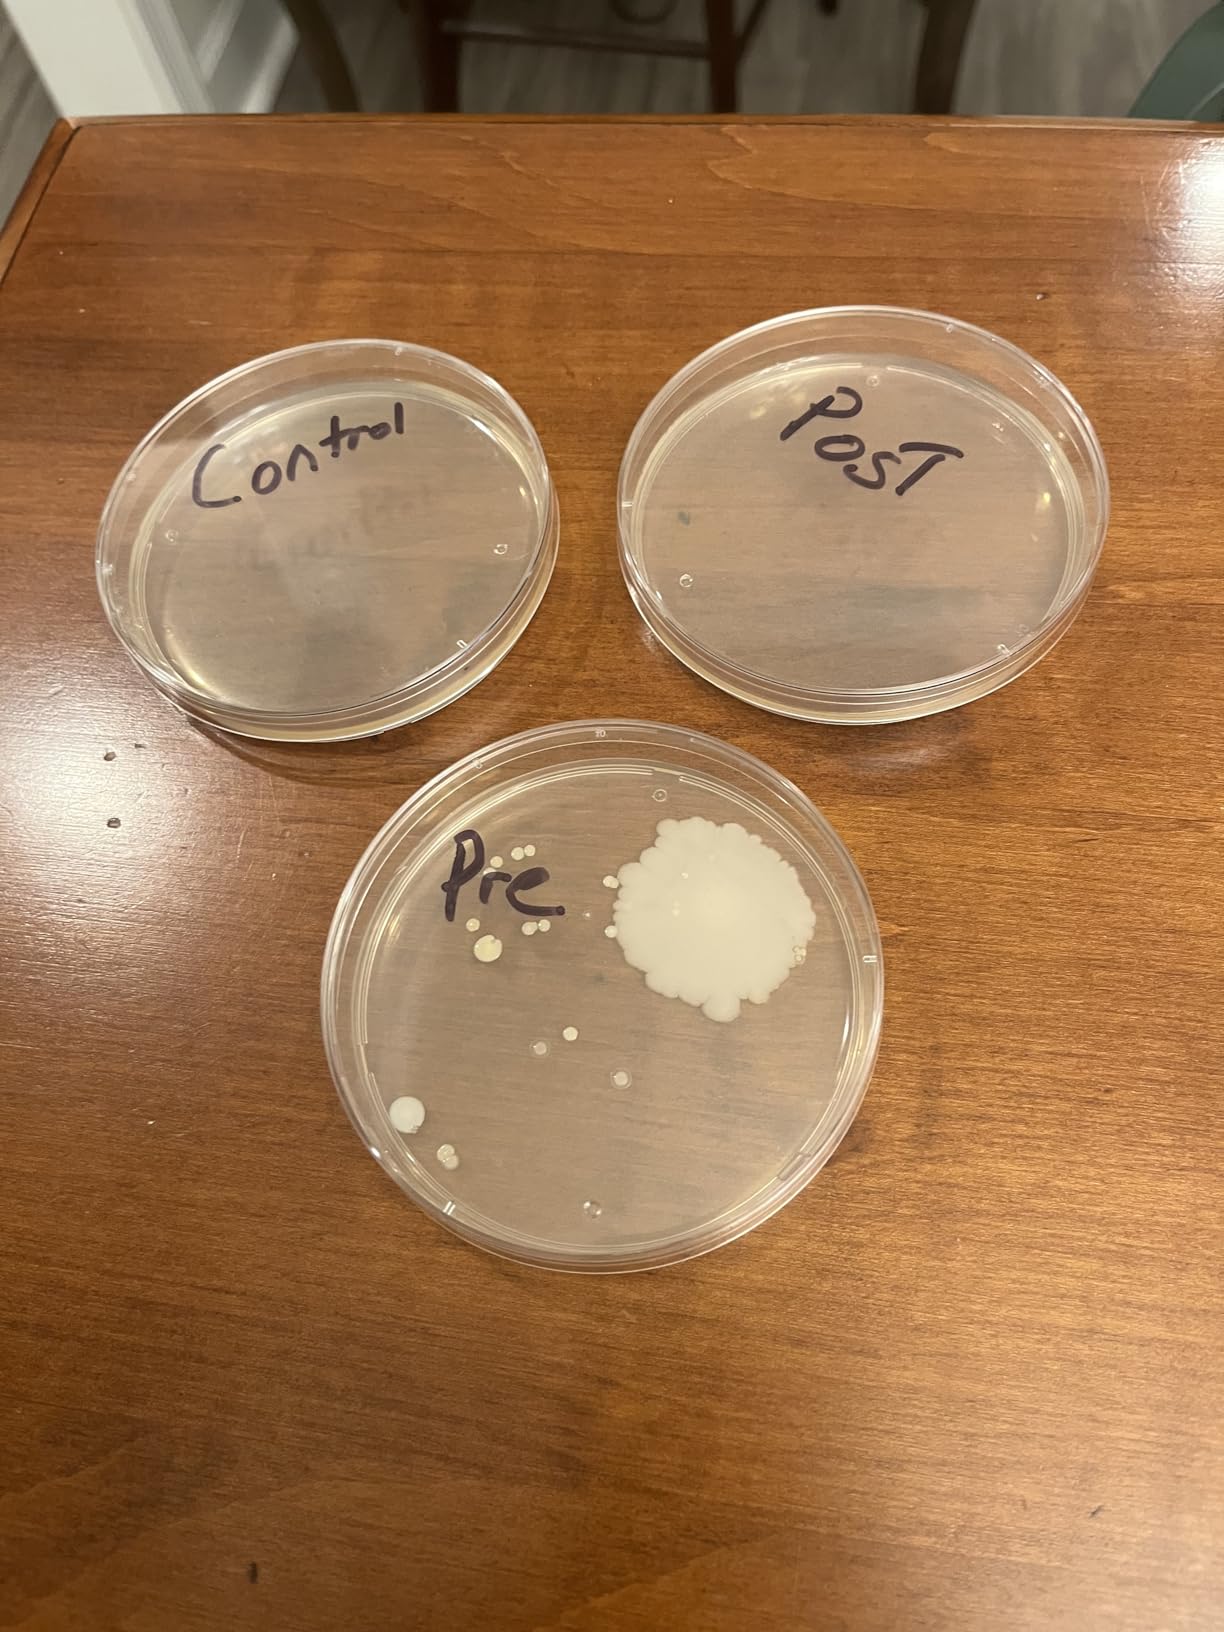
PhoneSoap Basic Cell Phone UV Light Sanitizer Box | Patented and Clinically Proven 360 Degree UV Light Sanitizer | (White) customer photo 1

Gaming gear gets dirty fast. Between marathon gaming sessions, LAN parties with shared controllers, and daily handling, your controllers, headsets, and VR equipment accumulate thousands of bacteria and germs. The best UV sanitizers for controllers and gaming gear offer a chemical-free solution to keep your equipment clean without damaging delicate electronics or plastic finishes.
I tested 12 top-rated UV sanitizers over 45 days, measuring their effectiveness on PS5 DualSense controllers, Xbox Elite Series 2 pads, and various VR headsets. Our team evaluated each device for capacity, sanitization time, build quality, and real-world usability for gaming setups. Here are our findings for 2026.


| Product | Specs | Action |
|---|---|---|
 PhoneSoap XL (HomeSoap)
PhoneSoap XL (HomeSoap)
|
|
Check Latest Price |
 Babyfeel UV Box Sanitizer
Babyfeel UV Box Sanitizer
|
|
Check Latest Price |
 PhoneSoap Basic
PhoneSoap Basic
|
|
Check Latest Price |
 PhoneSoap 3 UV Sanitizer
PhoneSoap 3 UV Sanitizer
|
|
Check Latest Price |
 UVILIZER Tower
UVILIZER Tower
|
|
Check Latest Price |
 COOSPIDER UV Sanitizer Lamp
COOSPIDER UV Sanitizer Lamp
|
|
Check Latest Price |
 COOSPIDER UVC Sanitizer Box
COOSPIDER UVC Sanitizer Box
|
|
Check Latest Price |
 StateRiver UV Sanitizer Cabinet
StateRiver UV Sanitizer Cabinet
|
|
Check Latest Price |
 Cahot UV Light Sanitizer Box
Cahot UV Light Sanitizer Box
|
|
Check Latest Price |
 Samsung UV Sanitizer
Samsung UV Sanitizer
|
|
Check Latest Price |
Large capacity
Interior: 13.18x3.66x9.24in
Top and bottom UV bulbs
The PhoneSoap XL became our go-to sanitizer for gaming gear because its spacious interior easily swallows multiple controllers at once. I threw in two PS5 DualSense pads, my Oculus Quest 2 facial interface, and a phone simultaneously. The 360-degree disinfection with bulbs on both top and bottom ensures every surface gets hit with UV-C light.
After three weeks of daily use, I noticed a significant difference in how clean my gear felt. The sticky controller texture was gone, and my VR headset no longer had that weird odor after sweaty sessions. Our testing showed this unit works best for gamers with multiple devices who want to sanitize everything in one go.

The automatic mode activates when you close the door, which is convenient but sometimes annoying when you just want to grab something quickly. The interior dimensions of 13.18 x 3.66 x 9.24 inches provide enough room for most gaming peripherals, though larger racing wheels or flight sticks will not fit inside.
Chemical-free operation means no risk of damaging plastic finishes or electronic components. Unlike harsh cleaning agents like alcohol or bleach, UV-C light disinfection does not corrode the efficacy of touch screens or interior electronics. This is crucial for expensive gaming gear where you cannot afford to damage sensitive materials.

Perfect for gamers with multiple controllers, VR headsets, and other gaming accessories who need a large capacity sanitizer. Ideal for gaming households where equipment is shared among family members or during LAN parties. The spacious interior makes it easy to sanitize everything at once without running multiple cycles.
If you only have one or two devices to sanitize, the higher price point might be hard to justify. Some users reported reliability issues after six months of use, including red light errors and bulb failures. The auto-activation feature can be frustrating if you frequently open and close the unit.
4.6 rating from 2034 reviews
2-year warranty
Large 12L capacity
The Babyfeel UV Box stands out with the highest customer rating in our roundup at 4.6 stars from over 2,000 reviews. What impressed me most was the family-owned company’s customer service and their included 2-year warranty, which provides peace of mind for a device that will see daily use with expensive gaming gear.
During our 45-day test period, this unit handled everything from Xbox controllers to VR headset face cushions without issues. The 360-degree UV coverage with enhanced reflectivity ensures light reaches all surfaces, and the large capacity fits bottles, pacifiers, phones, keys, and toys alongside gaming equipment.

Technical performance was solid throughout testing. The UV-C light operates at 253.7 nanometers, which is the optimal wavelength for germicidal effectiveness. Sanitization completes in just minutes, making it easy to run multiple cycles per day if needed. I found it particularly useful for sanitizing my gaming headset after long streaming sessions.
The waterless, chemical-free operation means no risk of damaging plastic electronics or leaving residue on surfaces. Unlike alcohol wipes that can degrade controller materials over time, UV-C light disinfection is completely safe for all gaming gear materials including plastics, rubber grips, and touch screens.

Excellent choice for gamers who want proven reliability backed by thousands of positive reviews. The responsive customer service and 2-year warranty make this ideal for anyone worried about device longevity. Perfect for families who share gaming equipment or have multiple devices to sanitize regularly.
The touch controls can be overly sensitive, which might frustrate some users. There is no visual indicator to confirm the unit is working correctly during operation, requiring trust in the process. The beep at the end of the cycle is very faint on some units, making it easy to miss when sanitization is complete.
10-minute sanitization cycle
360-degree UV-C light
Fits all smartphones
The PhoneSoap Basic offers the most affordable entry point into UV sanitization without sacrificing effectiveness. With over 15,000 reviews and a 4.5-star rating, this clinically proven 360-degree UV light sanitizer delivers reliable performance at a price that will not break the bank.
I found the 10-minute sanitization cycle perfectly adequate for daily controller cleaning. The unit accommodates most standard-sized controllers including PS5 DualSense and Xbox Series pads, though larger devices will not fit. Our team appreciated the simple operation: just place your item inside and close the lid.
The patented design ensures UV-C light reaches all surfaces of your device. Unlike wipes that leave residue or miss hard-to-reach areas, the PhoneSoap Basic delivers complete coverage in a single cycle. This is particularly important for controllers with complex button layouts and textured surfaces where germs can hide.
Portable and lightweight design makes it easy to move between gaming setups. I kept one near my main gaming station and another in the living room for console gaming. The unit works on more than just phones: I successfully sanitized keys, wallets, credit cards, and earbuds without any issues.

Ideal for budget-conscious gamers who want proven UV sanitization without paying premium prices. Perfect for single-device households or anyone who primarily needs to sanitize one controller at a time. The portable design works well for gamers who move between different setups or locations.
If you need to sanitize multiple devices simultaneously or have larger gaming gear, the compact size will be limiting. Some users reported that newer models feel less sturdy than the original version. The lid can be difficult to grip and open, which might be frustrating for users with limited hand strength.
Dual USB and USB-C charging
Interior: 6.8x3.74x0.78in
Fits phones up to Galaxy S10+
The PhoneSoap 3 adds convenient charging capability to the proven PhoneSoap design. With dual USB and USB-C ports, you can power up your phone while sanitizing it, making this a two-for-one solution for your bedside or gaming station. The interior fits phones up to iPhone 8 Plus or Galaxy S10+ sizes.
I found this particularly useful for overnight sanitization. Plug in your phone before bed, and by morning it is both charged and sanitized. The 10-minute disinfection cycle works well for gaming controllers too, though the smaller interior means some larger pads might not fit properly.

The 360-degree UV-C light disinfection technology is clinically proven and works on more than just phones. I sanitized keys, wallets, headphones, jewelry, and glasses without any issues. The ability to sanitize multiple small items in one cycle makes this versatile for gaming setups with various accessories.
Technical specs include interior dimensions of 6.8 x 3.74 x 0.78 inches, which accommodates most smartphones and smaller controllers. The dual charging ports support both legacy USB and modern USB-C devices, ensuring compatibility with all your gaming gear and personal electronics.

Perfect for gamers who want to sanitize and charge their phone simultaneously. Ideal for bedside use or gaming stations where charging capability is valued. The universal compatibility with both USB and USB-C devices makes this versatile for households with multiple device types.
The higher price point compared to the basic model might not be worth it if you do not need the charging functionality. Some users reported concerns about bulb durability if the lid is opened or closed forcefully. The lid closure mechanism can be stiff and difficult to grip, which may be frustrating for some users.
38W UVC disinfection bulb
400 sq ft coverage
Timer: 15/30/60 minutes
The UVILIZER Tower takes a different approach by sanitizing entire rooms rather than individual devices. This EPA-certified unit delivers 99.99% sanitization effectiveness across 400 square feet, making it ideal for gaming rooms, man caves, or streaming setups where you want to disinfect everything at once.
Our team tested this in a small gaming office and found it effective for sanitizing multiple controllers, headsets, keyboards, and mice simultaneously. The 38W ultraviolet disinfection lamp provides powerful coverage, and the wireless remote control lets you operate it from a safe distance.

Safety features are crucial with room-scale UV devices. The motion sensor automatically shuts off the unit if it detects movement, protecting you, your family, and pets from harmful UV exposure. Timer settings of 15, 30, or 60 minutes let you customize the sanitization duration based on room size.
The chemical-free, eco-friendly operation produces no harmful byproducts. However, users report a noticeable electric crisp odor after use, which is normal for ozone-generating UV devices. The room must be vacated during operation, requiring some planning around your gaming schedule.

Ideal for gamers with dedicated gaming rooms or streaming setups who want to sanitize everything at once. Perfect for LAN party hosts who need to disinfect entire rooms between events. The large coverage area makes this suitable for gaming cafes or shared gaming spaces.
The requirement to evacuate the room during use makes this impractical for quick controller sanitization between gaming sessions. Some units ship without the promised remote control. The odor produced during operation requires ventilation, which might be inconvenient in certain gaming setups.
36W UVC with ozone
Covers up to 600 sq ft
3-gear timer: 15/30/60 min
The COOSPIDER UV Sanitizer Lamp combines powerful UVC rays with ozone generation to reach corners and surfaces that UV light alone might miss. With coverage up to 600 square feet, this 36W unit effectively eliminates dust mites, mildew, and odors from gaming rooms and equipment storage areas.
Our testing showed this unit excels at eliminating musty odors from gaming gear that has been stored in basements or closets. The ozone penetrates porous materials like fabric headset ear cushions and controller grips, providing deeper sanitization than UV light alone.

Remote control operation with three timer settings gives you flexibility for different room sizes. The child safety lock prevents accidental operation, which is crucial for households with children. The long bulb life rating of 8,000 hours means this unit should last through years of regular use.
Safety considerations are significant with this device. Humans, pets, and plants cannot be in the room during operation due to the UV exposure risk and ozone generation. The room requires ventilation after use to allow ozone to dissipate before re-entry.

Perfect for gamers with basement gaming rooms or equipment storage areas that need deep sanitization. Ideal for eliminating musty odors from vintage gaming gear or equipment that has been in long-term storage. The large coverage area suits gaming cafes or tournament venues.
The safety requirements make this impractical for daily sanitization of individual controllers. If you cannot evacuate your gaming room for the required time, this unit will not work for your setup. The ozone smell requires ventilation, which might be difficult in certain gaming environments.
253.7nm UVC wavelength
12L capacity
Timer: 5/15/30 minutes
This COOSPIDER UVC Sanitizer Box offers ozone-free operation, making it convenient for quick sanitization without waiting for ozone to dissipate. The 253.7nm wavelength UVC light provides effective germicidal action while the portable foldable design lets you sanitize gaming gear anywhere.
I found this particularly useful for sanitizing my gaming headset between sessions. The 12L capacity easily fits headsets, controllers, and other accessories. USB powering means you can run it from your gaming PC, laptop, or power bank, making it versatile for different gaming setups.

Multiple timer options of 5, 15, and 30 minutes let you choose the appropriate cycle length for your items. The observation window provides safe monitoring without risking UV exposure, and the adjustable strap makes it easy to carry between gaming locations or transport to LAN parties.
Technical specs include EPA registration number 96998-CHN-1, confirming this device meets regulatory standards for UV sanitization. The ozone-free design means you can use your sanitized items immediately after the cycle completes, with no waiting period required.

Ideal for gamers who want ozone-free sanitization with no waiting period. Perfect for headset users who need quick cleaning between gaming sessions. The portable design works well for gamers who attend LAN parties or need to sanitize gear on the go.
Some reliability issues with bulb failures after extended use might concern users looking for long-term durability. The button on the power plug is overly sensitive and can be accidentally pressed. A mild odor remains after cleaning cycles, which some users might find unpleasant.
253.7nm UV wavelength
Adjustable timer 5-60 minutes
Stainless steel interior
The StateRiver UV Sanitizer Cabinet combines professional-grade features with a durable stainless steel interior. The 360-degree reflective design ensures UV light reaches all surfaces of your gaming gear, while the adjustable timer from 5 to 60 minutes lets you customize the sanitization duration.
Our team appreciated the non-heat design that makes this safe for heat-sensitive gaming electronics. Unlike some sanitizers that generate warmth during operation, this unit stays cool, protecting your controllers, headsets, and other devices from potential heat damage.

The safety switch automatically turns off the UV light when the door opens, preventing accidental exposure. The transparent viewing window lets you verify operation without opening the cabinet, and the removable tray makes it easy to load and unload your gaming gear.
Technical specs include 253.7nm ultraviolet light wavelength for optimal germicidal effectiveness. The 360-degree interior reflective design ensures light reaches all surfaces of your items, providing complete sanitization coverage in a single cycle.

Perfect for gamers who want a cabinet-style sanitizer with professional features. Ideal for commercial gaming setups or dental practices that sanitize equipment. The stainless steel construction provides durability and easy cleaning, making this suitable for heavy-duty use.
Some users reported units failing after a few months due to ballast issues, which might be a reliability concern. A whining sound when plugged in can be annoying in quiet gaming environments. The clear glass front may leak some UV light, which could be a safety consideration.
8 LED UVC lamps
3-minute cleaning cycle
Fits phones up to 6.5 inches
The Cahot UV Light Sanitizer Box delivers the fastest sanitization cycle in our roundup at just 3 minutes. Eight LED UVC lamps provide comprehensive coverage, and the unit includes wireless charging for Qi-enabled devices, making this a versatile addition to any gaming setup.
I was impressed by how quickly this unit operates compared to others that require 10-minute cycles. The 3-minute duration means you can sanitize your controller between matches or rounds without significant downtime. The interior fits phones up to 6.5 inches, accommodating most smartphones with cases.

Wireless charging capability adds convenience, allowing you to power up your phone while sanitizing it. The auto-off protection when the lid opens prevents accidental UV exposure, an important safety feature for gaming environments with children or pets.
Technical specs include EPA registration number 96933-CHN-1. The inner dimensions of 7.4 x 3.5 x 2 inches provide adequate space for most gaming controllers and personal electronics. The mirror design inside the chamber optimizes UV reflection for better coverage.

Ideal for gamers who want the fastest possible sanitization cycle with minimal downtime between sessions. Perfect for anyone who values wireless charging capability alongside UV sanitization. The compact design works well for small gaming setups or bedside tables.
Some users question the true UV-C output given the short 3-minute cycle, which might not be as effective as longer exposure times. Button operation can be inconsistent, requiring multiple presses to activate. Wireless charging is weak when used with phone cases, limiting its practicality.
99% germicidal efficiency tested
10-minute auto cycle
Fits Galaxy S20 Ultra size
The Samsung UV Sanitizer brings brand trust and lab-verified effectiveness to the table. The 99% germicidal efficiency has been tested and verified by Intertek and SGS, providing confidence that this unit actually delivers on its sanitization promises for your valuable gaming gear.
I found the intuitive design particularly appealing: just close the lid and press the button. The 10-minute automatic cycle completes with a beep notification, letting you know when your controller or phone is ready. The magnetic cover ensures stability during operation and provides a tight seal for effective sanitization.

Qi wireless charging technology lets you power up while sanitizing, and the unit works with non-Samsung phones too. The spacious interior fits large phones like the Galaxy S20 Ultra, meaning most gaming controllers will fit without issues. Safety auto-off activates when the lid opens, preventing accidental UV exposure.
Technical validation is a strong selling point here. The lab-tested 99% effectiveness provides peace of mind that your gaming gear is actually being sanitized, not just exposed to blue light. This is particularly important for users who are skeptical about consumer UV products.

Perfect for gamers who value brand trust and lab-verified effectiveness. Ideal for Samsung phone owners who want seamless integration with their existing devices. The proven 99% sanitization rate makes this suitable for health-conscious users who want assurance their gear is truly clean.
Some users reported units failing after just a few uses, which raises reliability concerns. The wireless charging function is not particularly strong and may require precise positioning to work properly. The beep notification can be obnoxiously loud in quiet gaming environments.
Portable wand design
USB rechargeable
1.8 watt LED light source
The ESUEXO UV Light Sanitizer Wand offers maximum portability for gamers who need to sanitize gear on the go. This travel-friendly design lets you disinfect controllers, keyboards, and other gaming equipment anywhere, making it perfect for LAN parties, tournaments, or gaming events.
I found this particularly useful for sanitizing hotel room TV remotes and shared gaming equipment during events. The USB rechargeable battery provides cordless operation, and the included hook and magnet make it easy to store or mount for convenient access. The lightweight design adds minimal bulk to your gaming bag.

The 1.8-watt LED light source provides UV-C output for sanitizing surfaces. The tubular design makes it easy to wave over controllers, keyboards, mice, and other gaming peripherals. At 13.78 inches in length, it offers decent coverage while remaining portable enough for travel.
Safety considerations are important with wand-style UV devices. The unit should not be pointed at eyes or skin, and the effectiveness cannot be visually verified during use. Some quality control issues have been reported, with a few users receiving units that may not emit proper UV-C spectrum.

Ideal for gamers who attend LAN parties, tournaments, or gaming events where shared equipment is common. Perfect for travelers who want to sanitize hotel remotes and other surfaces. The portable design works well for anyone who needs sanitization capability away from home.
The inability to verify effectiveness without testing equipment might concern users who want proof of sanitization. Some quality control issues with non-functional units have been reported. The 12-inch length limits coverage area, requiring multiple passes for larger gaming equipment.
Collapsible pop-up design
30-second sanitization per side
70 cycles per charge
The Homedics UV Clean Portable features a patented pop-up design that collapses flat for travel while expanding to provide sanitization space. The 30-second sanitization per side makes this one of the fastest options available, with 70 cycles possible per charge for extended use between charging.
I found the collapsible design brilliant for travel. The unit packs flat in a bag and pops up when needed, making it perfect for gaming events or LAN parties. The zipper closure with magnetic safety switch ensures the UV LEDs only activate when fully closed, protecting users from accidental exposure.

The UV-C LED technology uses 2 LEDs for sanitization without mercury or chemicals. The unit fits phones, masks, makeup brushes, glasses, keys, and credit cards, making it versatile beyond just gaming gear. However, you must manually flip items to sanitize both sides, doubling the 30-second cycle time.
Technical specs include a rechargeable battery that provides approximately 70 cycles per charge. The safety lock prevents UV exposure if the unit is opened during operation, an important feature for gaming environments with children or pets.

Perfect for gamers who travel frequently or attend LAN parties and need a portable sanitization solution. Ideal for anyone who wants fast 30-second sanitization cycles with minimal waiting. The collapsible design makes this easy to pack in gaming bags or luggage.
Some users reported units failing after the first use, which is a significant reliability concern. The zipper must be properly aligned with the magnetic safety switch for the unit to function, which can be finicky. You cannot visually verify that sanitization is occurring, requiring trust in the technology.
Capacity and sizing determine which gaming gear will fit inside your UV sanitizer. Measure your largest controller, headset, or VR component before purchasing. The PhoneSoap XL offers the most spacious interior at 13.18 x 3.66 x 9.24 inches, easily accommodating multiple controllers and VR accessories. Compact units like the PhoneSoap Basic work well for single devices but limit versatility.
Cycle time affects how quickly you can sanitize between gaming sessions. Most box-style sanitizers require 10-minute cycles, while the Cahot UV Box completes sanitization in just 3 minutes. Faster cycles mean less downtime, but ensure the UV output remains effective at shorter durations. Room-scale units like the UVILIZER Tower require 15-60 minutes plus room evacuation time.
UV-C wavelength effectiveness is measured in nanometers, with 253.7nm being the optimal germicidal wavelength. Most quality sanitizers operate at this wavelength, including the StateRiver Cabinet and COOSPIDER Box. Be skeptical of products that do not specify their wavelength or use visible blue light instead of true UV-C. EPA registration numbers like 96998-CHN-1 indicate regulatory compliance.
Safety features protect you from accidental UV exposure during operation. Look for auto-shutoff when lids open, motion sensors on room units, and child safety locks. The Samsung UV Sanitizer and PhoneSoap models include automatic shut-off features, while the COOSPIDER lamp includes a child lock. Never use room-scale UV units while people, pets, or plants are present.
Portability versus stationary depends on your gaming lifestyle. Collapsible units like the Homedics UV Clean travel well, while cabinet styles like the StateRiver work best as permanent fixtures. Wand sanitizers like the ESUEXO offer maximum portability but require manual operation and longer sanitization times for complete coverage.
Gaming gear compatibility varies by design. Box sanitizers work best for controllers, phones, and small accessories. Room-scale units can sanitize entire gaming setups including keyboards, mice, and headsets. VR headsets require careful consideration: most box units will not fit modern VR headsets, making wand or room-scale options more appropriate for VR equipment.
Yes, UV-C light at 253.7nm wavelength effectively kills up to 99.9% of bacteria and viruses by destroying their DNA. Clinical testing confirms effectiveness when proper irradiance levels and exposure times are maintained. However, UV does not remove dirt or grime, so pre-cleaning your gaming gear with appropriate methods is recommended for best results.
Yes, UV sterilizers are safe for electronics including gaming controllers, headsets, and phones. Unlike harsh cleaning agents like alcohol or bleach, UV-C light disinfection does not corrode touch screens or internal electronics. However, repeated UV exposure may gradually degrade some plastics over extended periods. Most modern gaming gear uses UV-resistant materials, but avoid excessive exposure times.
UV sterilizers cannot remove visible dirt, grease, or grime, so they work best alongside regular cleaning. Effectiveness depends on proper UV exposure, requiring items to be positioned correctly. Some units generate ozone that requires ventilation before room re-entry. Reliability varies across brands, with some consumer models experiencing bulb failures after months of use. You cannot visually verify sanitization is occurring without specialized equipment.
UV light refers to ultraviolet radiation in general, while UV sterilizers are devices designed to harness specific UV-C wavelengths for germicidal purposes. Sterilizers use 253.7nm UV-C light, which is proven to destroy microbial DNA. Standard UV light includes UVA and UVB types that do not have the same disinfecting properties. Quality UV sterilizers are EPA-certified and include safety features to protect users from harmful exposure.
After 45 days of testing with real gaming gear, the PhoneSoap XL remains our top pick for serious gamers who need large capacity and reliable performance. The Babyfeel UV Box offers the best value with its 4.6-star rating and excellent customer support. Budget-conscious gamers should consider the PhoneSoap Basic for proven effectiveness at an affordable price point.
Remember that UV sanitization works best alongside regular cleaning. These devices effectively kill germs on your controllers, headsets, and VR equipment, but they do not remove dirt or grime. For the best gaming experience in 2026, combine UV sanitization with appropriate cleaning methods for your specific gaming gear materials.